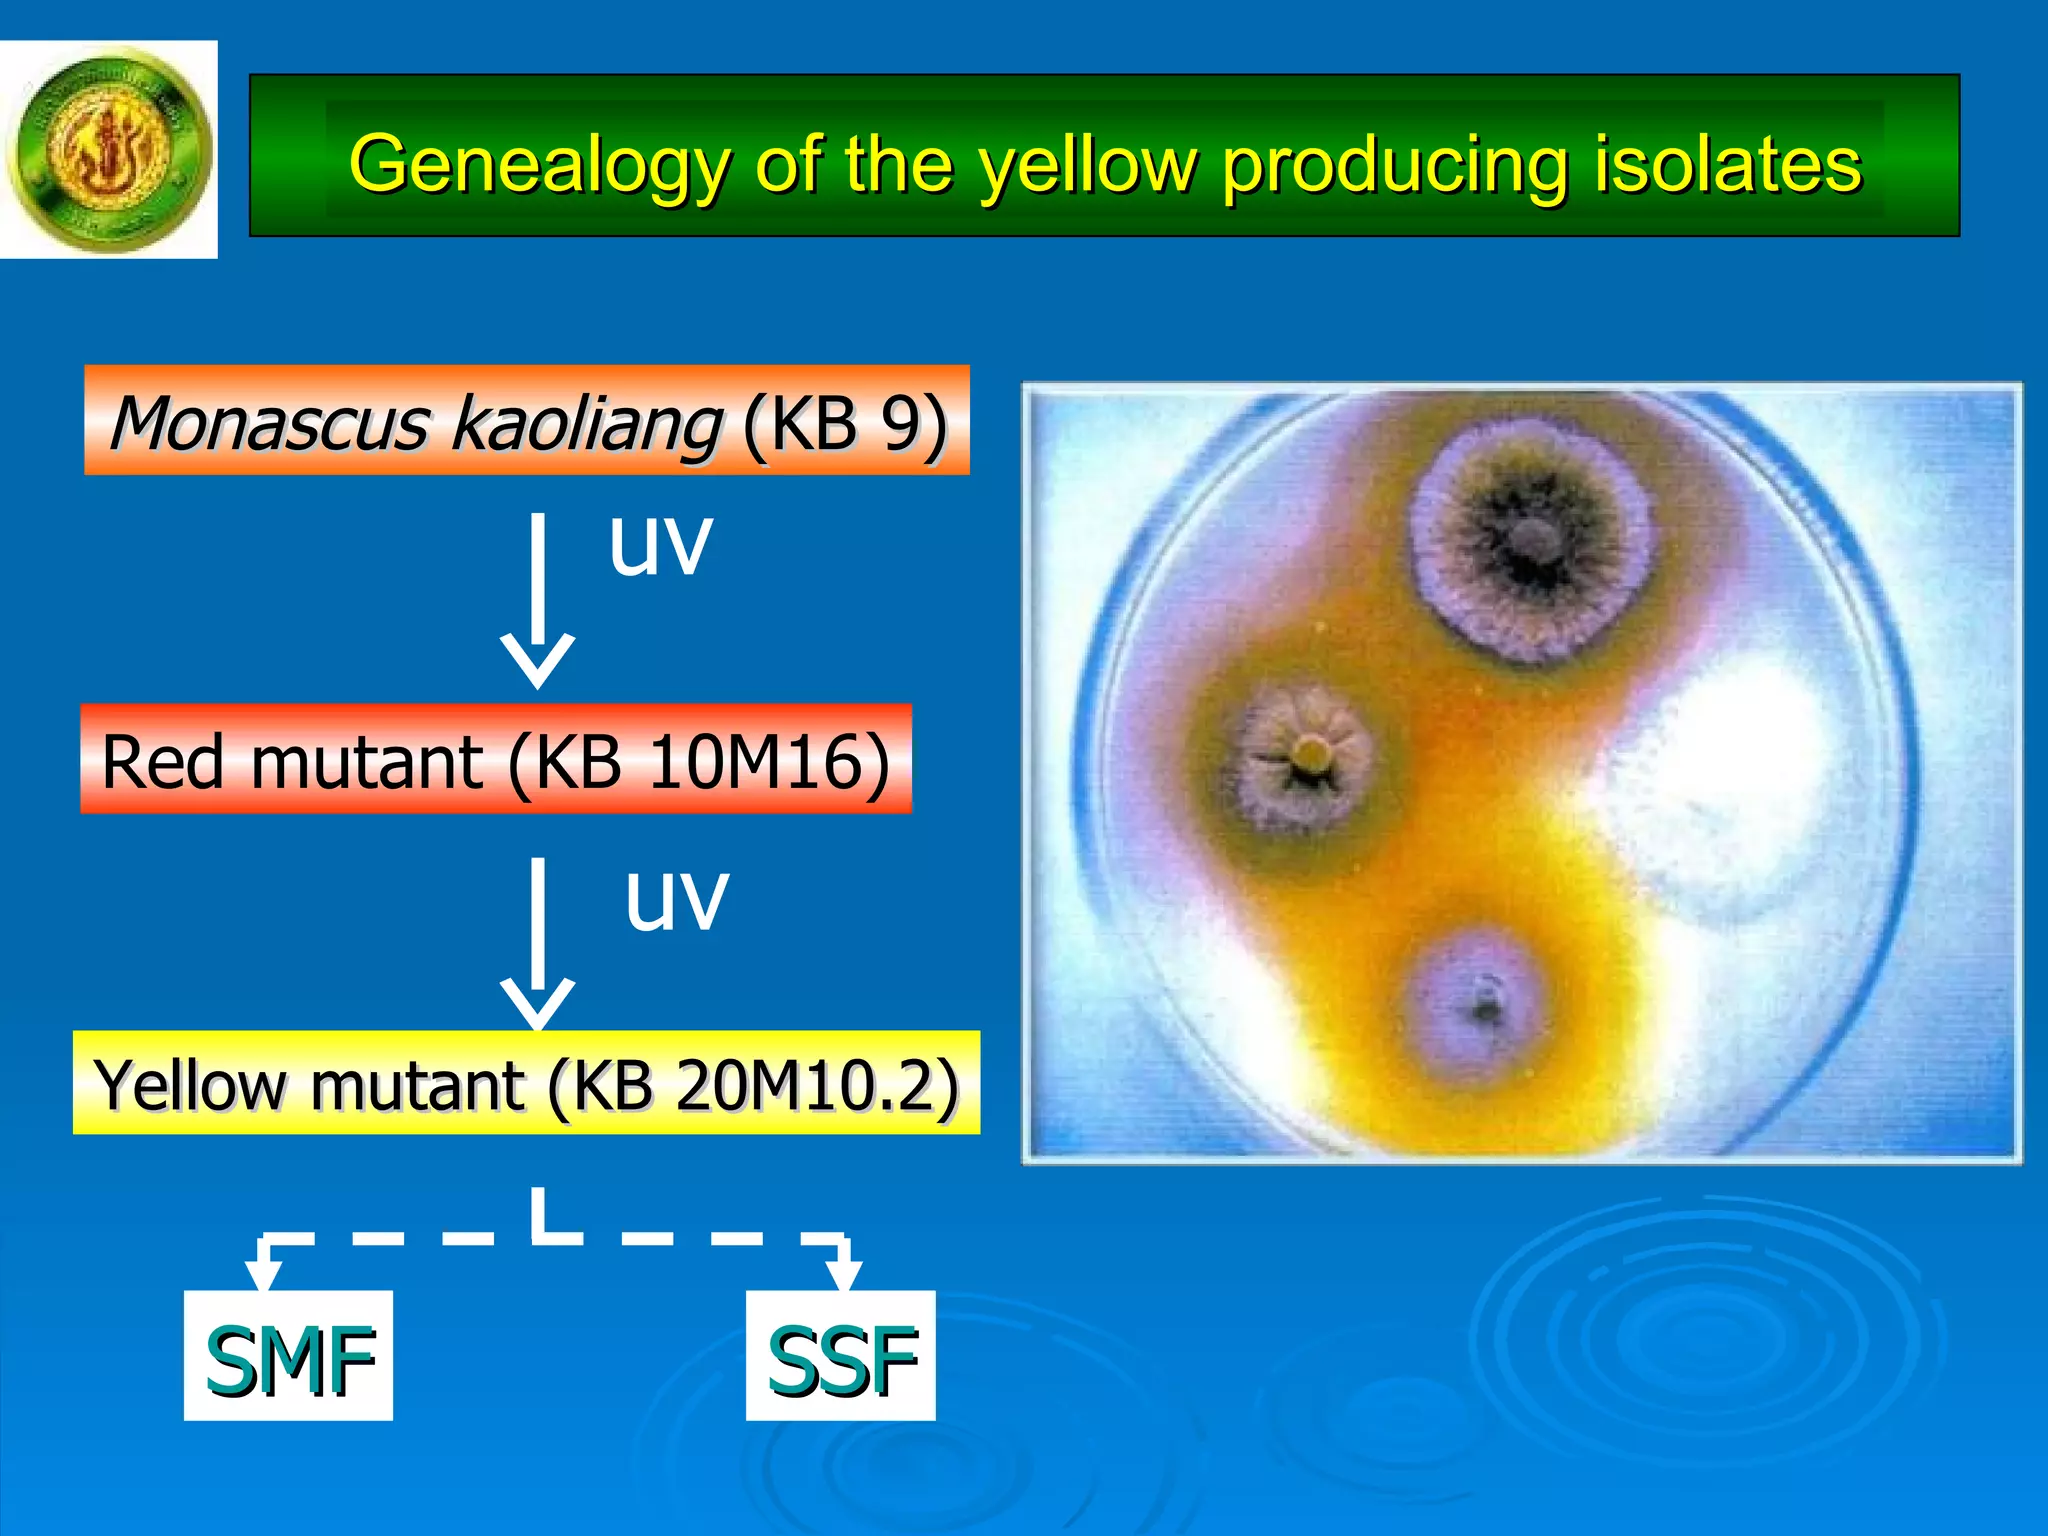
Monascus kaoliang  (KB 9) uv Red mutant (KB 10M16) uv Yellow mutant (KB 20M10.2) SMF SSF Genealogy of the yellow producing isolates
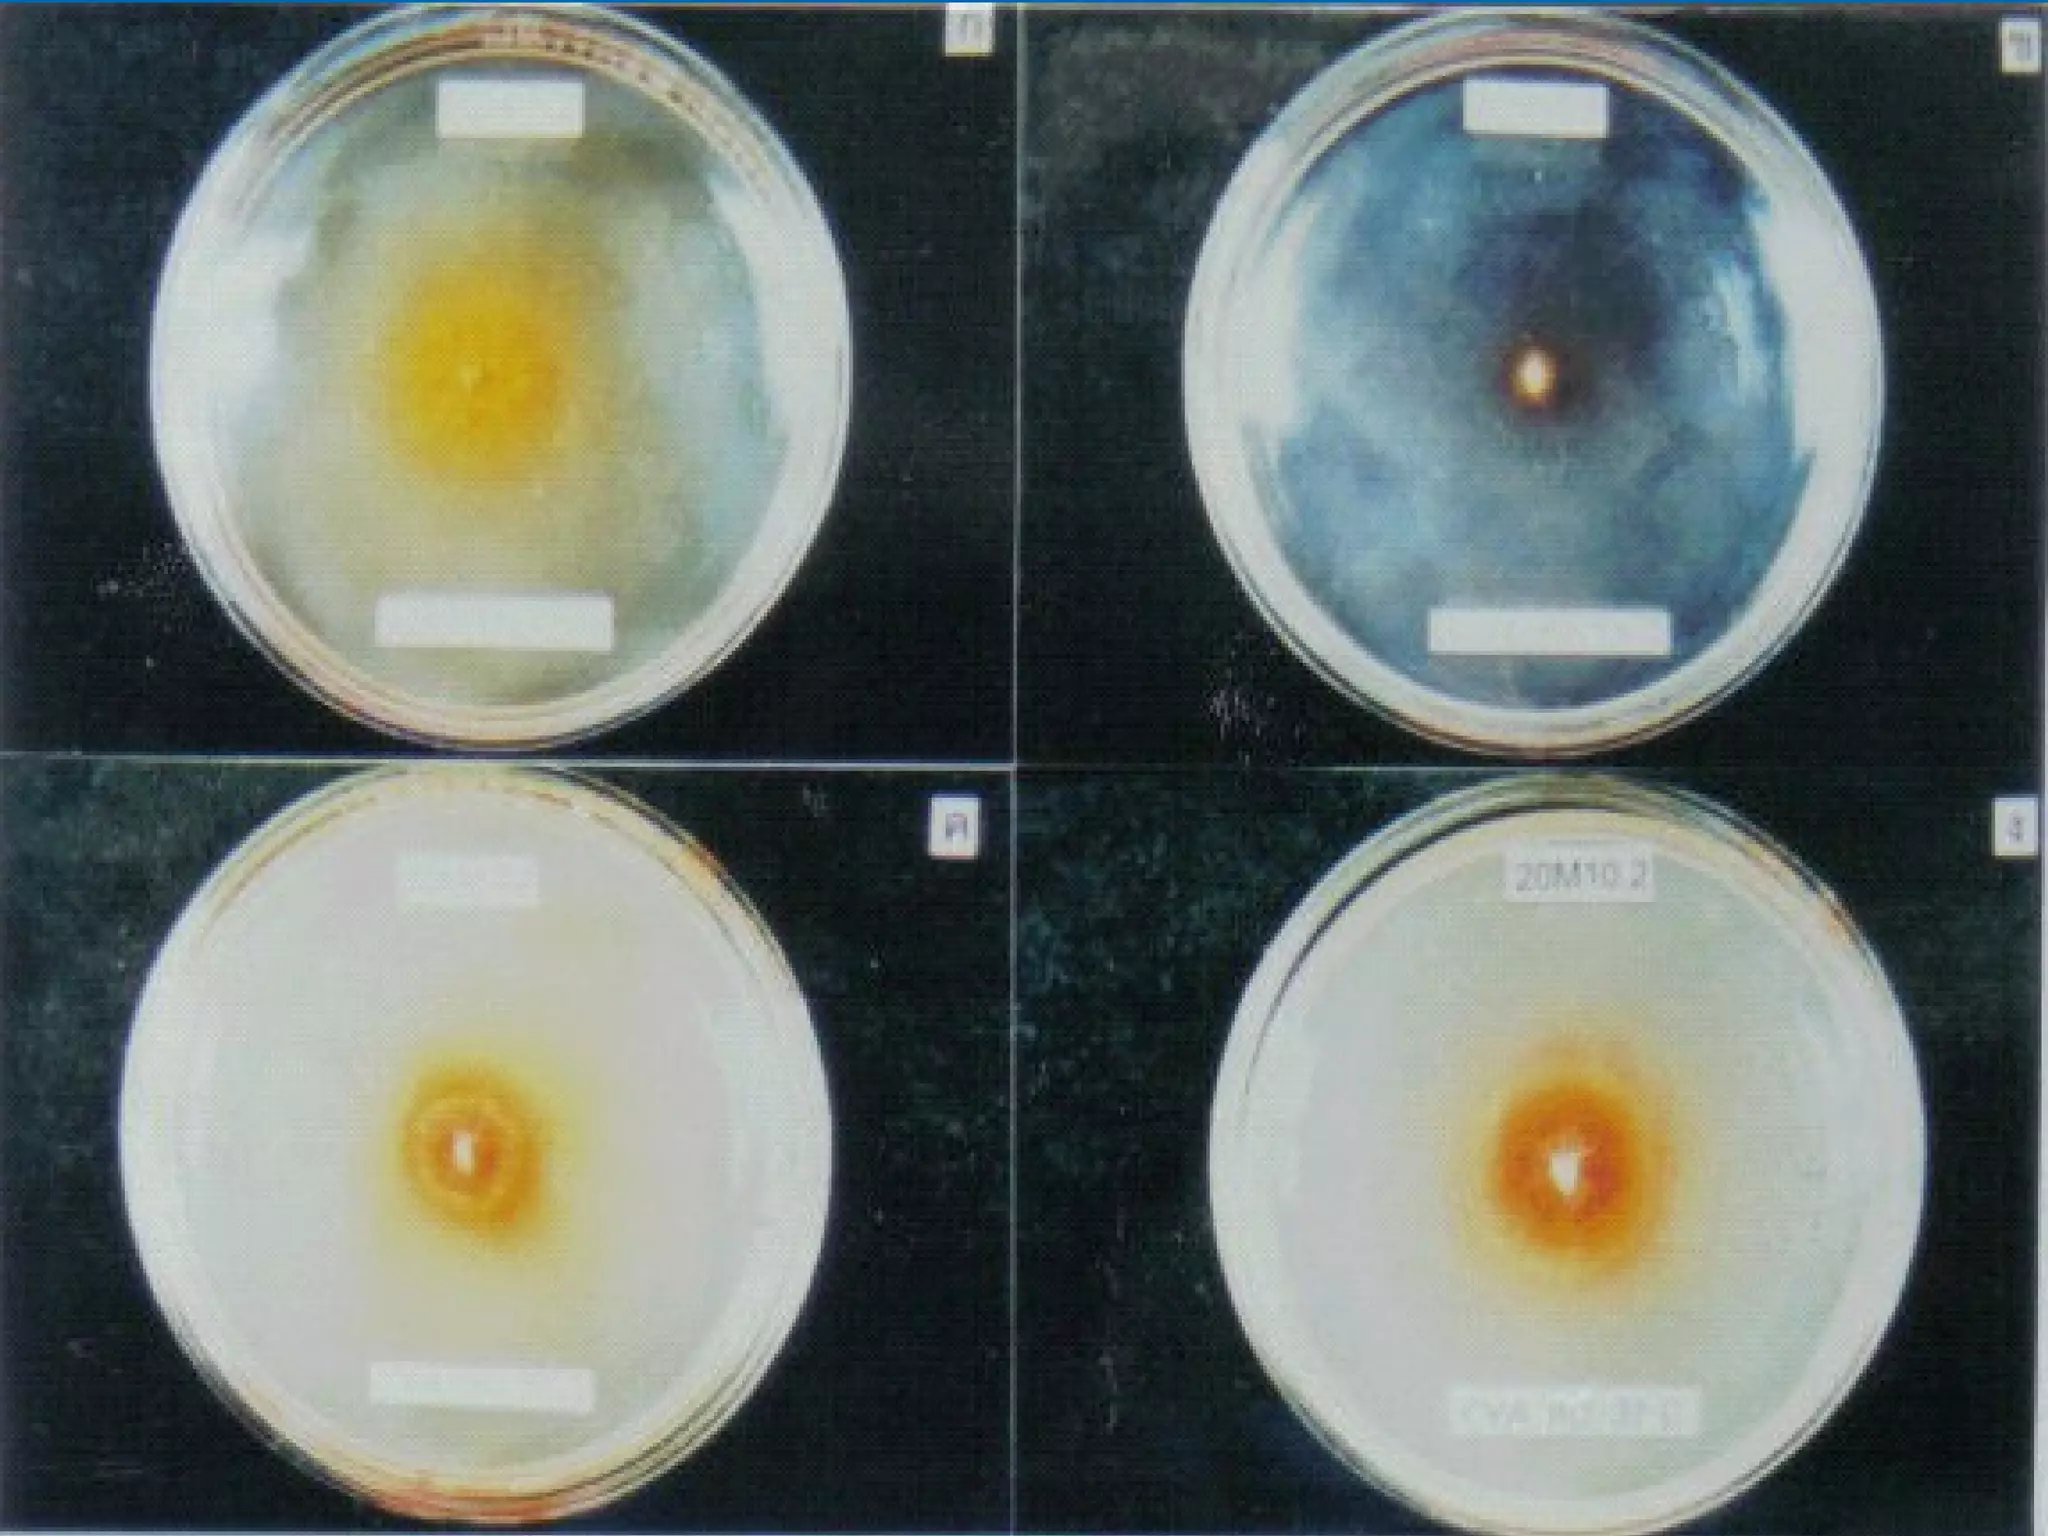
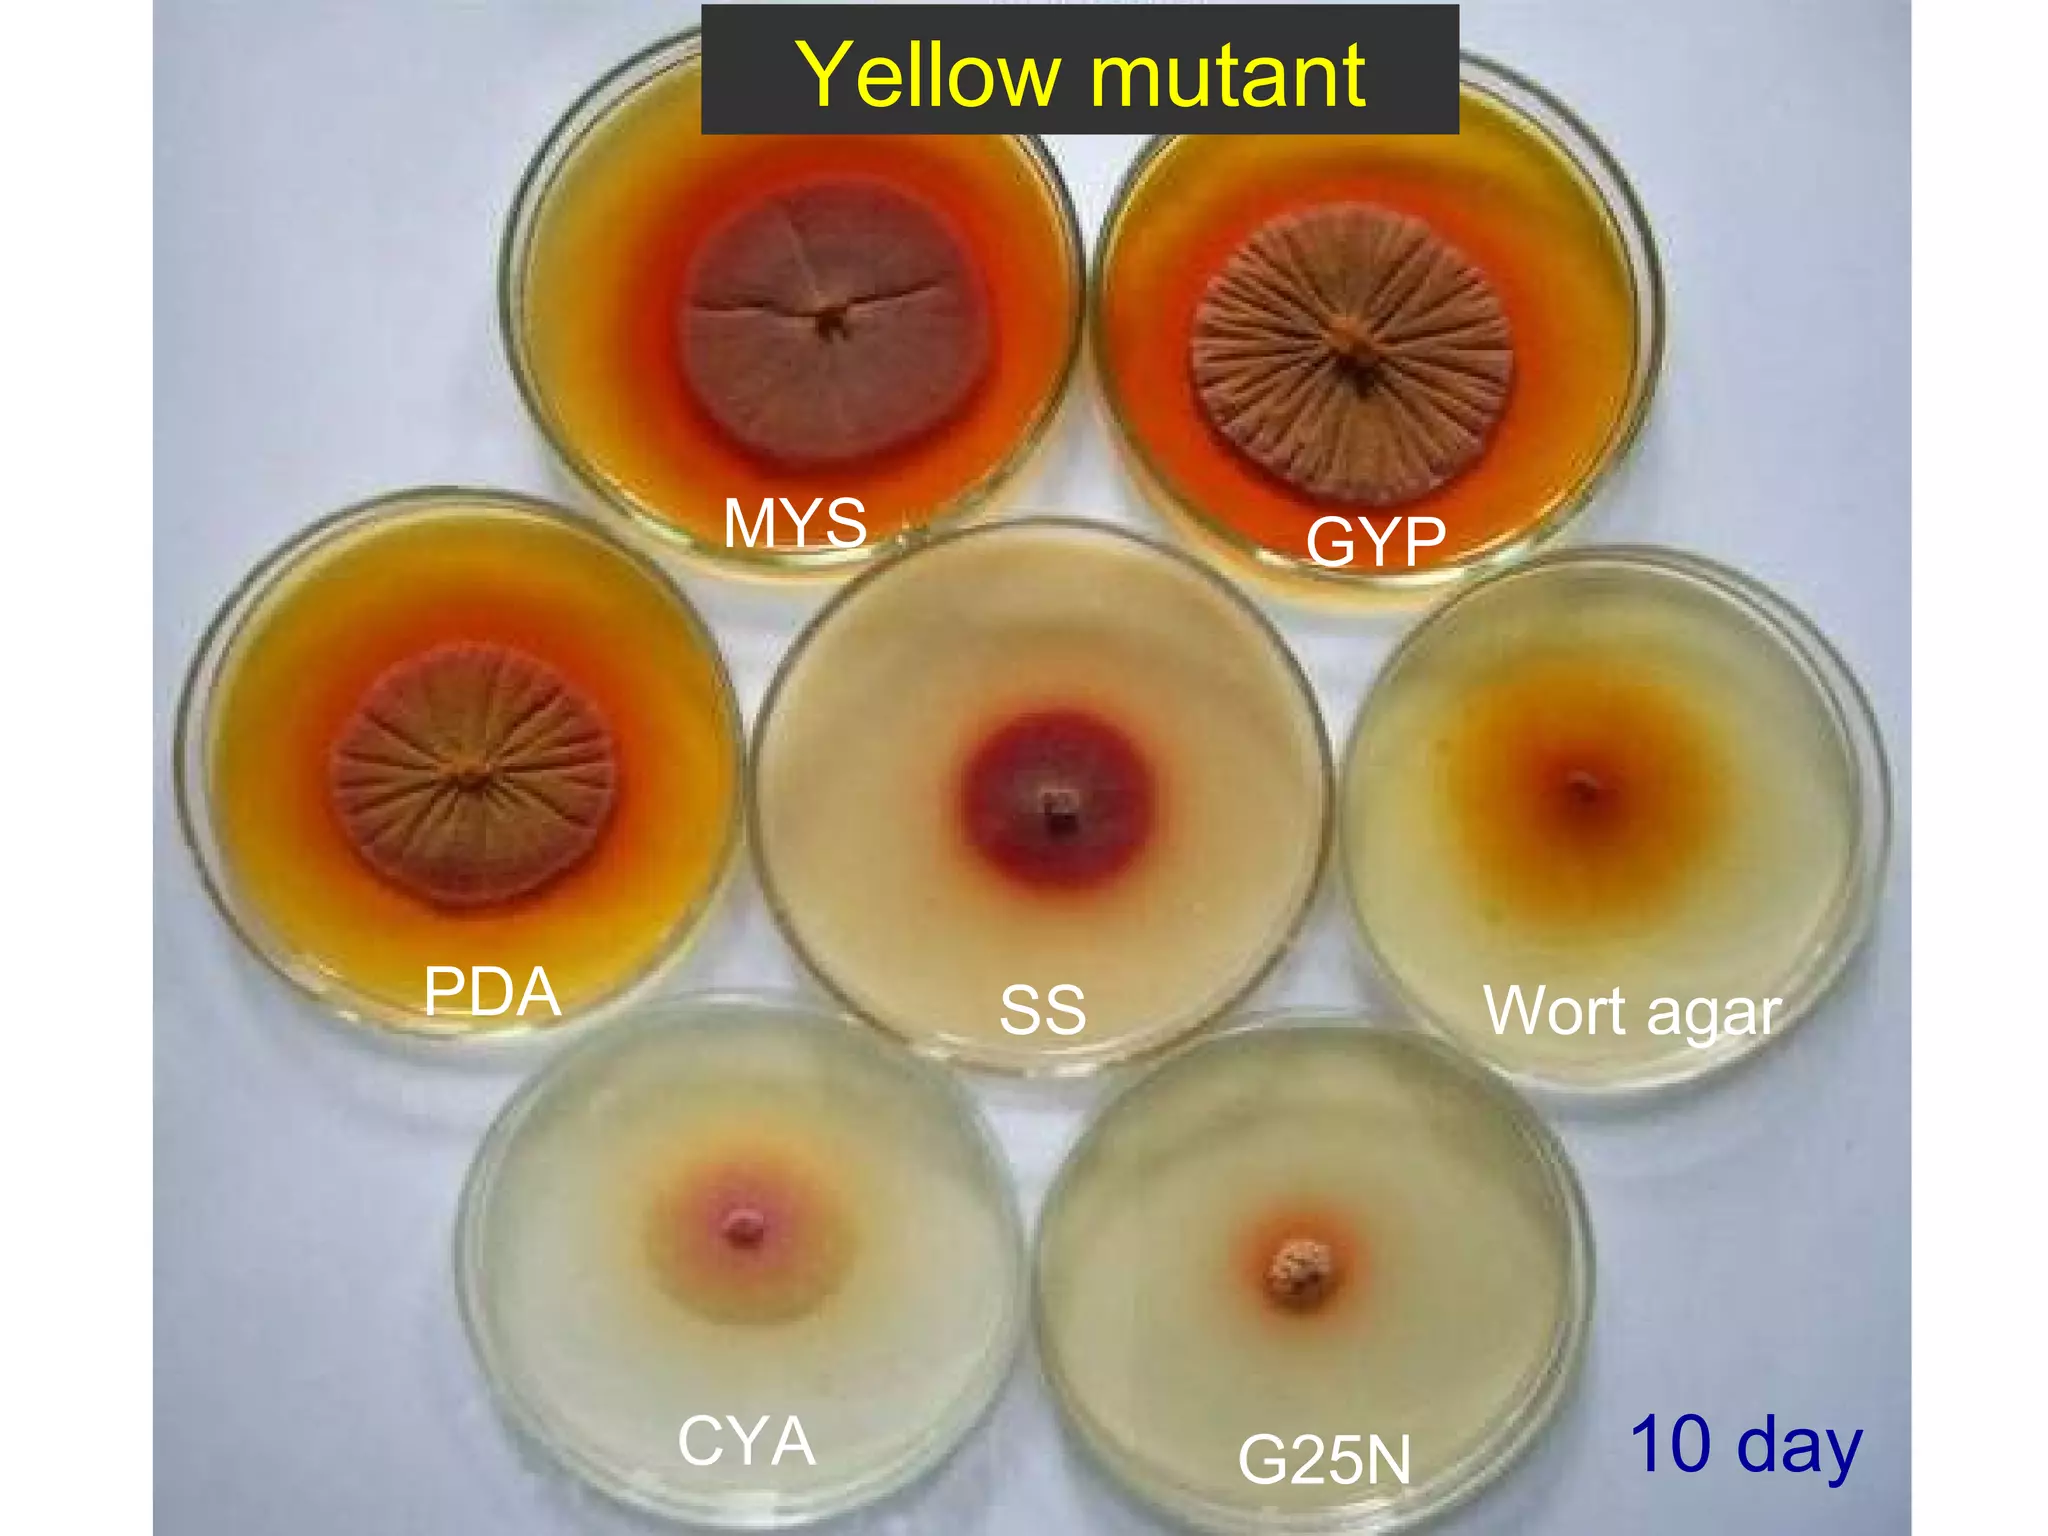
10 day CYA G25N Wort agar PDA GYP SS MYS Yellow mutant

The document discusses the production and value creation of yellow pigments from a mutant strain of Monascus kaoliang, focusing on its antimutagenic and antioxidant properties. It details various experiments, including extraction and testing methods, that demonstrate the potential of monascus pigments as safe food colorants with health benefits. Additionally, it highlights the implications for food applications, showcasing the strain’s ability to produce significant antioxidant compounds.